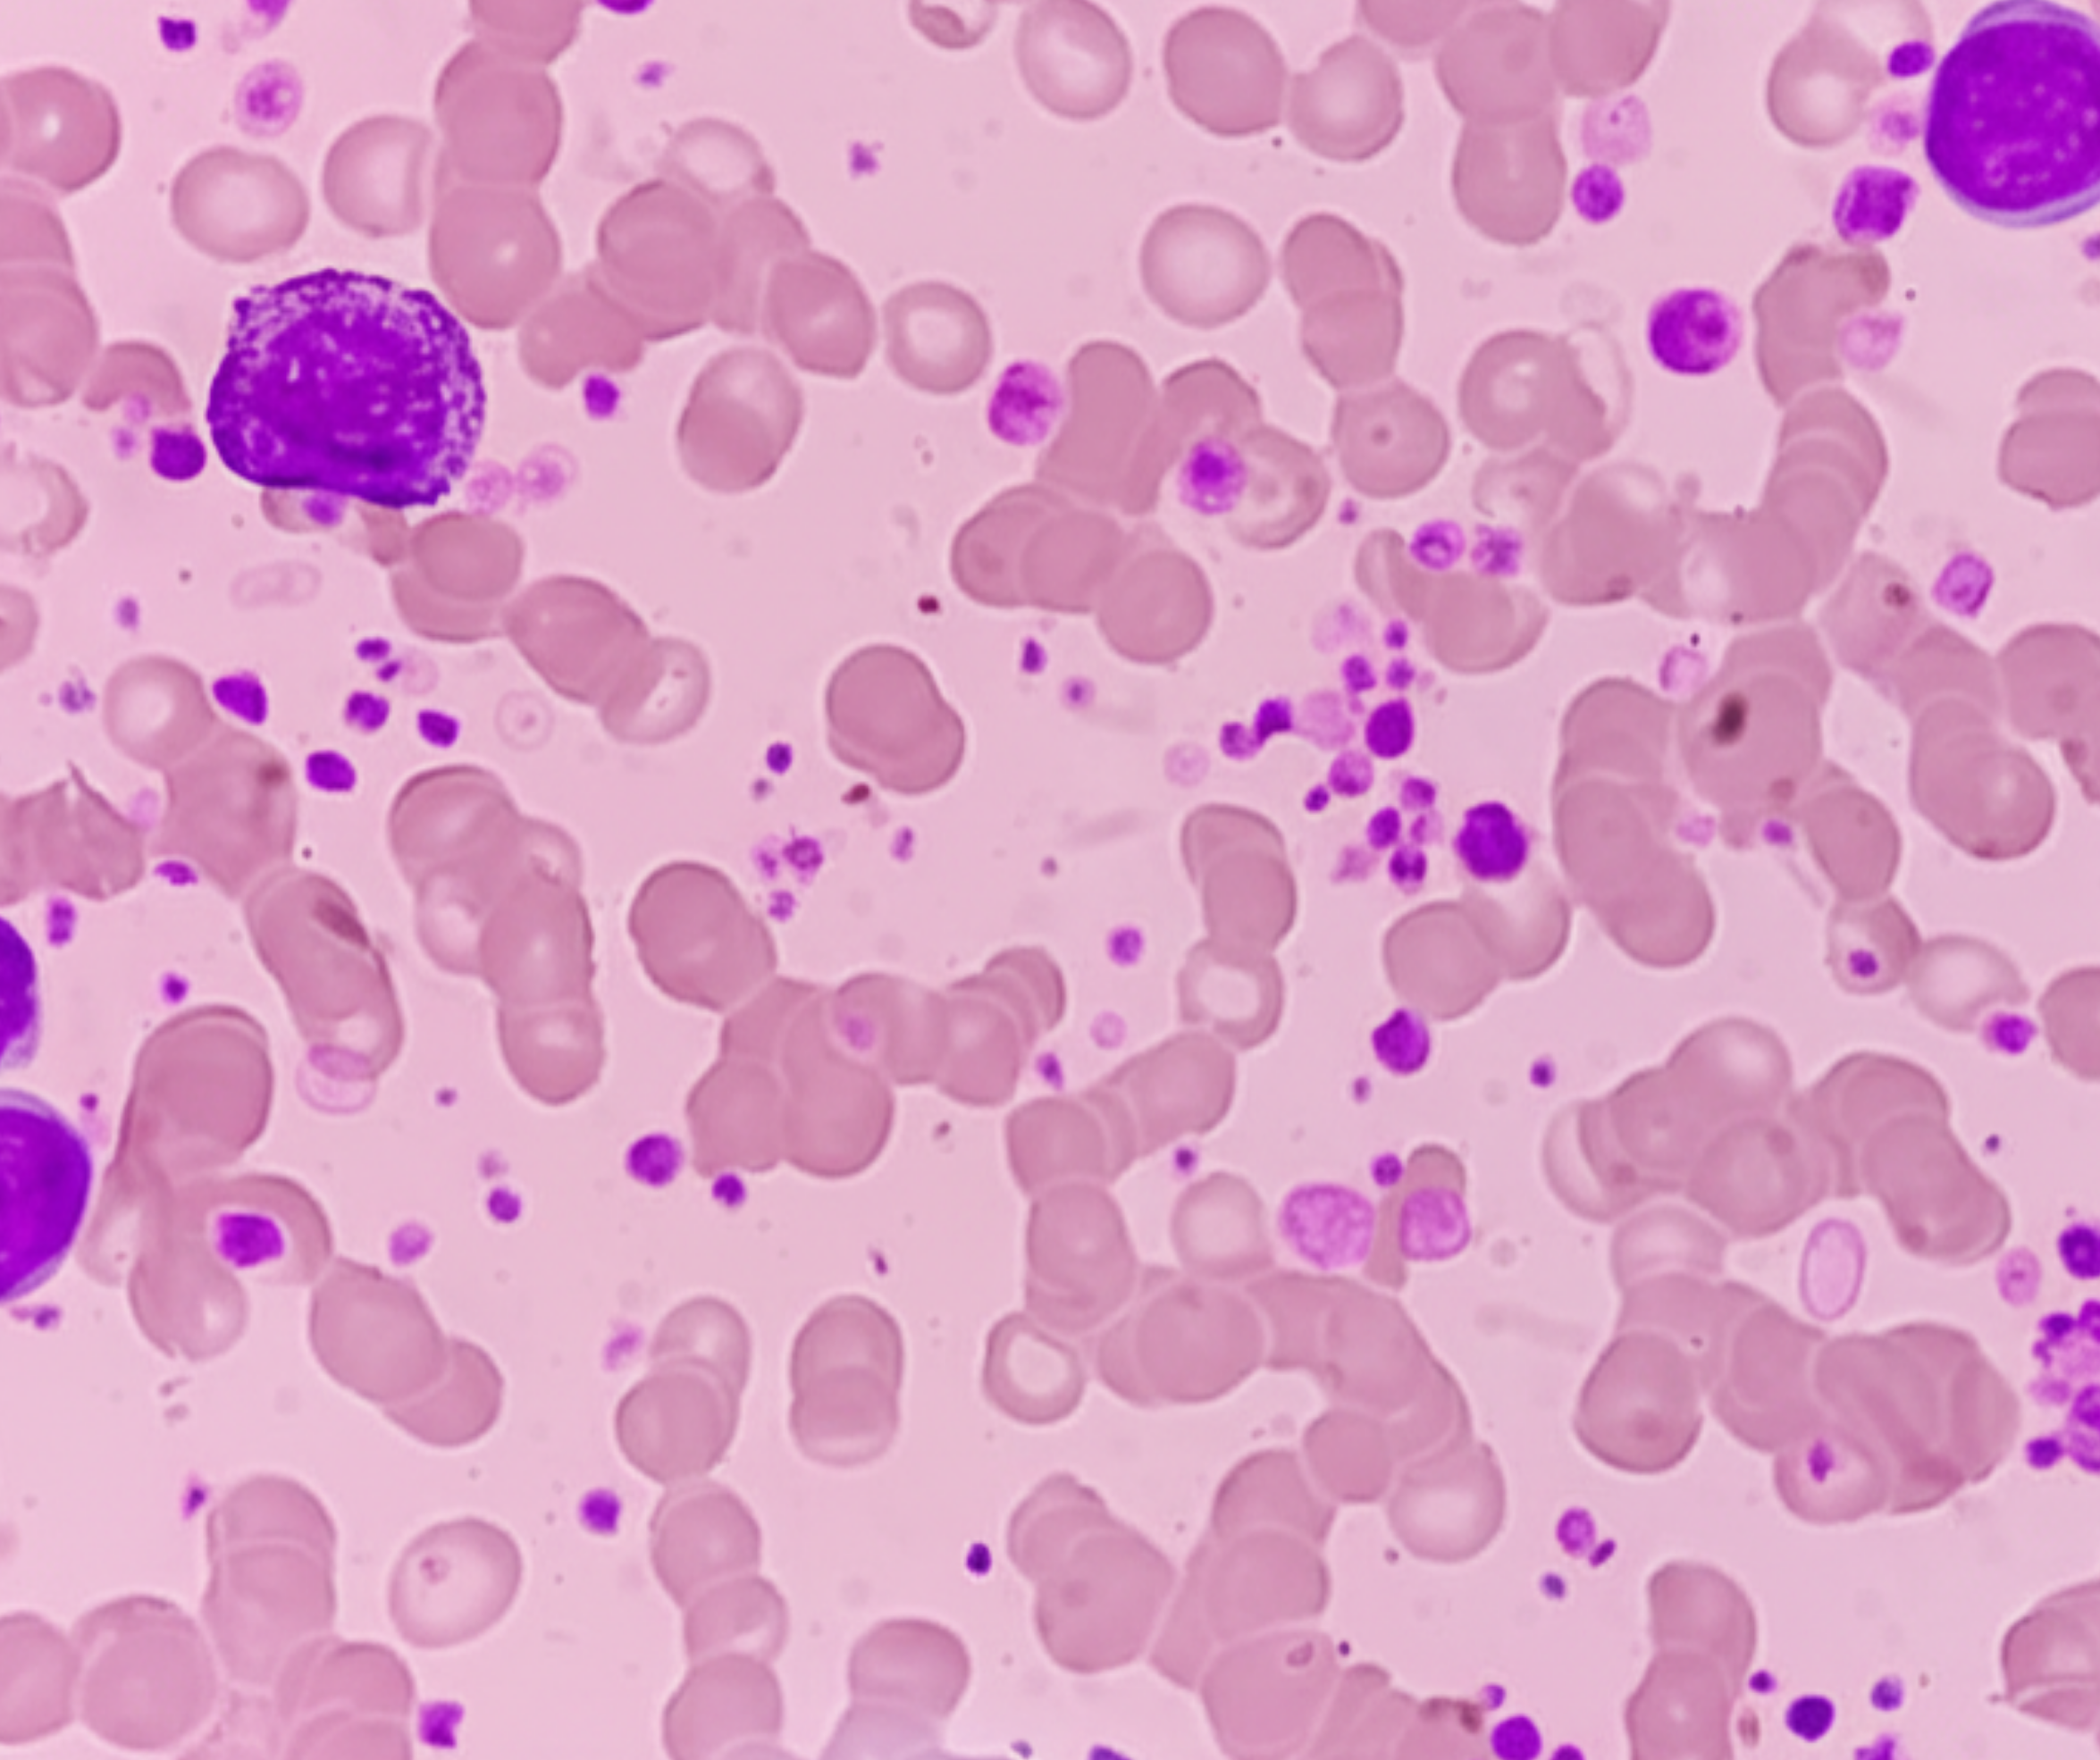
Understanding How Inherited Gene Variants Shape Blood Cancer Risk

The RUNX1 Pulse blog is a resource for insights, education, and updates around RUNX1-FPD. This blog covers a variety of topics, from breaking down complex research papers into patient-friendly language to exploring key biology concepts. We share stories and expert insights to keep everyone informed about the latest advancements in RUNX1-FPD research and care. Interested in contributing or reposting your existing blog? Please contact Catherine Pelton, RRP’s Director of Communications, via email.